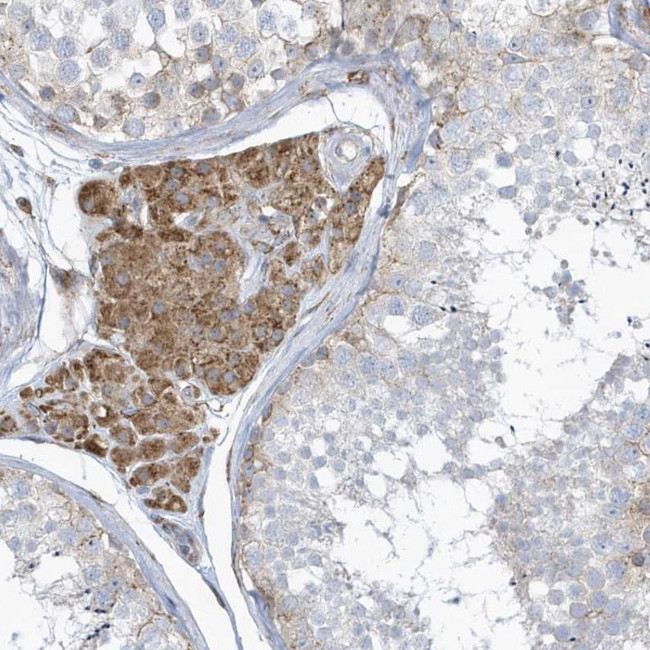
VPRBP Antibody in Immunohistochemistry (Paraffin) (IHC (P))

Search
Invitrogen
VPRBP Polyclonal Antibody
{{$productOrderCtrl.translations['antibody.pdp.commerceCard.promotion.promotions']}}
{{$productOrderCtrl.translations['antibody.pdp.commerceCard.promotion.viewpromo']}}
{{$productOrderCtrl.translations['antibody.pdp.commerceCard.promotion.promocode']}}: {{promo.promoCode}} {{promo.promoTitle}} {{promo.promoDescription}}. {{$productOrderCtrl.translations['antibody.pdp.commerceCard.promotion.learnmore']}}
产品信息
PA5-57541
种属反应
宿主/亚型
分类
类型
抗原
偶联物
形式
浓度
规格
纯化类型
保存液
内含物
保存条件
运输条件
RRID
产品详细信息
Immunogen sequence: FTCCAFSARE RFLMLGTCTG QLKLYNVFSG QEEASYNCHN SAITHLEPSR DGSLLLTSAT WSQPLSALWG MKSVFDMKHS FTEDHYVEFS KHSQDRVIG
Highest antigen sequence identity to the following orthologs: Mouse - 100%, Rat - 100%.
靶标信息
Acts both as a substrate recognition component of E3 ubiquitin-protein ligase complexes and as an atypical serine/threonine-protein kinase, playing key roles in various processes such as cell cycle, telomerase regulation and histone modification. Probable substrate-specific adapter of a DCX (DDB1-CUL4-X-box) E3 ubiquitin-protein ligase complex, named CUL4A-RBX1-DDB1-DCAF1/VPRBP complex, which mediates ubiquitination and proteasome-dependent degradation of proteins such as NF2. Involved in the turnover of methylated proteins: recognizes and binds methylated proteins via its chromo domain, leading to ubiquitination of target proteins by the RBX1-DDB1-DCAF1/VPRBP complex. The CUL4A-RBX1-DDB1-DCAF1/VPRBP complex is also involved in B-cell development: VPRBP is recruited by RAG1 to ubiquitinate proteins, leading to limit error-prone repair during V(D)J recombination. Also part of the EDVP complex, an E3 ligase complex that mediates ubiquitination of proteins such as TERT, leading to TERT degradation and telomerase inhibition. Also acts as an atypical serine/threonine-protein kinase that specifically mediates phosphorylation of 'Thr-120' of histone H2A (H2AT120ph) in a nucleosomal context, thereby repressing transcription. H2AT120ph is present in the regulatory region of many tumor suppresor genes, down-regulates their transcription and is present at high level in a number of tumors. Involved in JNK-mediated apoptosis during cell competition process via its interaction with LLGL1 and LLGL2. In case of infection by HIV-1 virus, it is recruited by HIV-1 Vpr in order to hijack the CUL4A-RBX1-DDB1-DCAF1/VPRBP function leading to arrest the cell cycle in G2 phase, and also to protect the viral protein from proteasomal degradation by another E3 ubiquitin ligase. The HIV-1 Vpr protein hijacks the CUL4A-RBX1-DDB1-DCAF1/VPRBP complex to promote ubiquitination and degradation of proteins such as TERT and ZIP/ZGPAT. In case of infection by HIV-2 virus, it is recruited by HIV-2 Vpx in order to hijack the CUL4A-RBX1-DDB1-DCAF1/VPRBP function leading to enhanced efficiency of macrophage infection and promotion of the replication of cognate primate lentiviruses in cells of monocyte/macrophage lineage.
仅用于科研。不用于诊断过程。未经明确授权不得转售。
篇参考文献 (0)
生物信息学
蛋白别名: DDB1- and CUL4-associated factor 1; HIV-1 Vpr-binding protein; MGC102804; protein VPRBP; Serine/threonine-protein kinase VPRBP; unnamed protein product; Vpr (HIV-1) binding protein; Vpr-binding protein; Vpr-interacting protein; VprBP
基因别名: DCAF1; KIAA0800; RIP; VPRBP
UniProt ID: (Human) Q9Y4B6
Entrez Gene ID: (Human) 9730